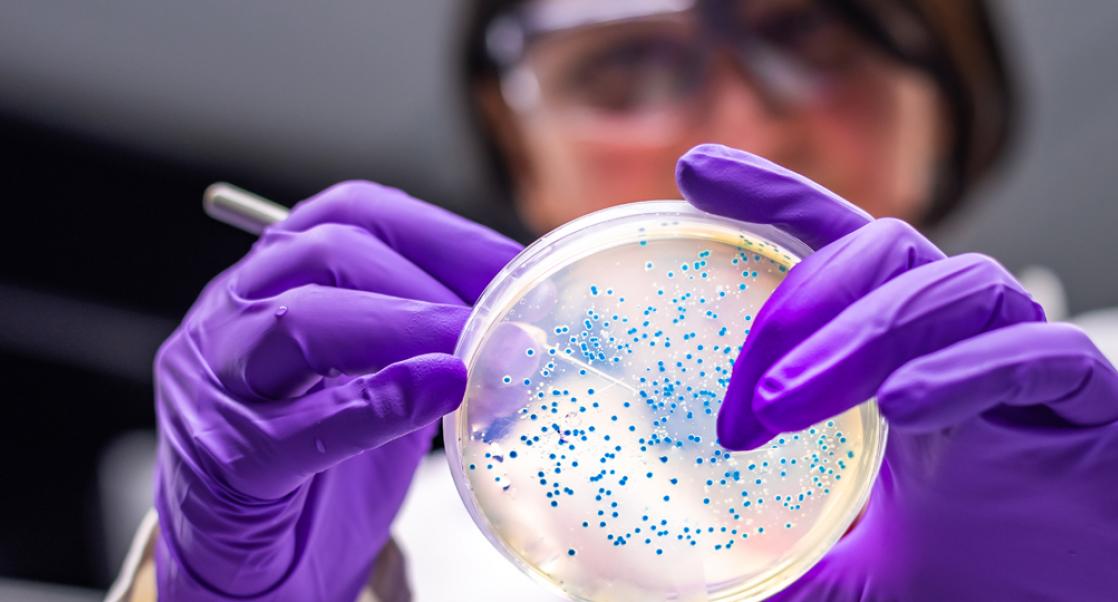
Microbiology Core Competencies and Control in the Facility

Microbial Solutions
|
Tara Cassidy
Leveraging Next-Generation Sequencing in Quality Control Testing of Novel Foods
How NGS is revolutionizing QC testing in the emerging industry of cell-based meats
As the world grapples with feeding a burgeoning population and mitigating climate change, novel foods, particularly cell-based meats, have emerged as a sustainable solution. However, ensuring the safety and quality of these innovative food products is paramount. Compared with traditional food processing, lab-grown meat comes with new hurdles and technology requirements. Next-generation sequencing (NGS) plays a crucial role in the quality control (QC) testing of these novel foods. This article delves into how NGS is revolutionizing QC testing in the emerging food industry.
What Are Novel Foods?
Novel foods are defined slightly differently across regions.
For example, the EU and UK define them as ‘any food that was not used for human consumption to a significant degree within the United Kingdom (UK) or the European Union (EU) before 15 May 1997. This means that the foods don’t have a ‘history of consumption’1.
The ‘history of consumption’ is a key qualifier in Australia and New Zealand2 and Singapore3 as well, with some small differences. Australia and New Zealand go further to include products derived from food that does not itself have a history of consumption. This would of course include cell-based meat, despite the fact that the cells come from known safe products.
Other examples of novel foods include phytosterols and phytostanols used in cholesterol reducing spreads; traditional foods eaten elsewhere in the world like chia seeds and baobab; and foods produced from new processes like bread treated with UV light to increase vitamin D.
Cell-Based Meat and Regulations
Cell-based meat, developed using biotechnology, tissue engineering, and synthetic processing, is at the forefront of novel foods. Singapore is leading the way in regulating these foods, followed by the US, with other countries like China, Japan, Australia/New Zealand and the EU developing their frameworks. These regulations necessitate stringent QC testing to ensure safety.
The Singapore Food Agency (SFA) released guidelines for novel foods, they were the first country to have cell-based meat approved for sale in the market globally. The scope of the guidelines is to ‘provide food businesses with a better understanding on the SFA’s requirements regarding the safety assessment for novel foods and novel food ingredients.’ On their website they have a 19-page self-checklist for cell-based meat that can be used for any submission to ensure sufficient information is provided for approval by the regulator.3
The Role of NGS in Quality Control Testing for Novel Foods
Every step in the manufacturing process must be QC checked to ensure it is safe. There are new hazards that must be considered for cell-based meat. Therefore, more modern techniques including NGS are required to ensure QC is effective and the product can pass regulations for market release.
In some areas of the regulations, NGS is specifically mentioned. In others, NGS can play a vital role to fulfill the QC requirements. Such areas include:
- Identification of Genetic Material: Whole Genome Sequencing (WGS) can be used to identify and characterize genetic material in novel foods, including the cell-lines used for production. This is essential for ensuring the safety and authenticity of the products.
- Confirmation of the cell-line's source: Transcriptomics and WGS can be used to confirm the origin or source of the cell-line used in novel food production.
- Contamination detection: NGS (transcriptomics) is effective in detecting pathogens, viruses, and other contaminants that might be present in cell cultures, ensuring the microbiological safety of the food.
- Anti-microbial resistance (AMR) tracking: NGS can be used to search for AMR genes and conclude if there is potential for anti-microbials to contribute to AMR in comparison with the traditional foods.
- Identification of possible allergens: NGS can help identify allergens by searching genomic results against allergen databases.
- Monitoring Genetic Stability: In cell-based meat production, maintaining genetic stability of the cell lines is crucial. NGS provides detailed insights into the genetic makeup, helping in monitoring any significant genetic variations.
NGS provides a comprehensive analysis of genetic material, ensuring novel foods are safe for consumption. By employing NGS in QC testing, producers can meet the stringent regulatory requirements set by various countries. NGS supports innovation in the food industry by providing robust tools for QC, thus fostering the development of new, sustainable food sources.

On-demand Webinar: How Next Generation Sequencing Is Transforming Microbial IDs
Traditional sequencing methods, such as Sanger and MALDI-TOF, can be limited in what they can offer. NGS technologies shatter these limitations by addressing needs that cannot be met with compendial methods. Listen to Tara Cassidy as she sheds a light on the "how" in this on-demand webinar.
Watch Now
NGS in Action
NGS provides a more detailed and comprehensive analysis compared to traditional methods, crucial for the safety and quality of novel foods. With its precision and depth, NGS helps producers meet diverse and stringent regulatory standards across different countries. NGS represents the future of food safety testing, supporting the sustainable production of novel foods such as cell-based meats. It accomplishes this through the following methods:
- Cell Line Verification: A study showcased NGS’s ability to verify the identity and source of cell lines, a crucial step for ensuring product authenticity.
- Virus Detection: In another case, NGS was employed to detect bacteriophages in cell cultures, highlighting its precision in identifying potential contaminants.
- Process Control: NGS was used to monitor fermentation processes in novel food production, demonstrating its utility in ensuring the consistency and safety of the production process.
Conclusion
The integration of next-generation sequencing in QC testing is a significant advancement in ensuring the safety and quality of novel foods. As the world shifts towards sustainable food sources, technologies like NGS not only support compliance with stringent safety regulations but also foster innovation in the food industry. The potential of cell-based meat and other novel foods in addressing global food challenges is immense, and NGS plays a pivotal role in realizing this potential.
References:
1. United Kingdom. Food Standards Agency. Novel foods authorization guidance. Novel foods and their status. January 2024.
2. Food Standards Australia New Zealand. Business Guidance, Novel Foods, June 2022.
3. Singapore Food Agency. Requirements for the Safety Assessment of Novel Foods and Novel Food Ingredients. Version dated 26 September 2022.
Tara Cassidy is an Account Manager with the Microbial Solutions Team.